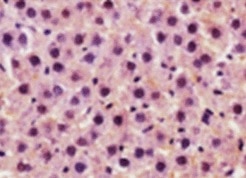

| Reactivity | Hu, Mu, RtSpecies Glossary |
| Applications | WB, IHC, KO |
| Clone | 625509 |
| Clonality | Monoclonal |
| Host | Mouse |
| Conjugate | Unconjugated |
| Immunogen | E. coli-derived recombinant human Bcl-2 Ala2-Asp211 Accession # P10415 |
| Specificity | Detects human Bcl-2 in direct ELISAs and Western blots. In direct ELISAs, approximately 25‑40% cross‑reactivity with recombinant mouse (rm) Bcl‑2 is observed and no cross-reactivity with recombinant human BCL2L12 is observed. In Western blots, 100% cross-reactivity with rmBcl-2 is observed. |
| Source | N/A |
| Isotype | IgG2b |
| Clonality | Monoclonal |
| Host | Mouse |
| Gene | BCL2 |
| Purity Statement | Protein A or G purified from hybridoma culture supernatant |
| Innovator's Reward | Test in a species/application not listed above to receive a full credit towards a future purchase. |
| Dilutions |
|
|
| Reviewed Applications |
|
|
| Publications |
|
| Storage | Use a manual defrost freezer and avoid repeated freeze-thaw cycles.
|
| Buffer | Lyophilized from a 0.2 μm filtered solution in PBS with Trehalose. *Small pack size (SP) is supplied either lyophilized or as a 0.2 µm filtered solution in PBS. |
| Preservative | No Preservative |
| Reconstitution Instructions | Sterile PBS to a final concentration of 0.5 mg/mL. |
Bcl-2 is a member of a family of proteins that regulates outer mitochondrial membrane permeability (1, 2). Bcl-2 is an anti-apoptotic member that prevents release of cytochrome c from the mitochondria intermembrane space into the cytosol. Bcl-2 is present on the outer mitochondrial membrane and is also found on other membranes in some cell types. Natural Bcl-2 contains a carboxyl-terminal mitochondria targeting sequence. Recombinant Bcl-2, missing the mitochondrial targeting sequence, maintains its ability to neutralize pro-apoptotic Bcl-2 family members. Neutralization by Bcl-2 appears to be through binding the BH3 region of pro-apoptotic Bcl-2 family members. This activity does not require the mitochondrial targeting sequence.
| Images | Ratings | Applications | Species | Date | Details | ||||||||
|---|---|---|---|---|---|---|---|---|---|---|---|---|---|
Enlarge |
reviewed by:
Verified Customer |
IHC-Fr | Mouse | 08/20/2021 |
Summary
|
Secondary Antibodies |
Isotype Controls |
|
Read full blog post. |
|
Losing memory: Toxicity from mutant APP and amyloid beta explain the hippocampal neuronal damage in Alzheimer's disease By Jamshed Arslan Pharm.D. Alzheimer's disease (AD) is an irreversible brain disorder that destroys memory and thinking skills. The telltale signs of AD brains are extracellular deposits of amy... Read full blog post. |
|
Autophagy independent roles of the core ATG proteins By Christina Towers, PhD. Autophagy and ATG ProteinsAutophagy is a nutrient recycling process that cells use to fuel metabolism, particularly in response to nutrient deprivation. It is critical for removal of dam... Read full blog post. |
|
Key Targets in Apoptosis, Necroptosis, and Autophagy Cell death/recycling pathways such as apoptosis, necroptosis, and autophagy are an integral part of the growth, development, homeostasis as well as the pathophysiology in the life of living organisms. These signaling pathways are highly regulated and ... Read full blog post. |
|
Altered expression of BCL2 in cancer Similar to other cell processes, the balance between cell survival and cell death is an important equilibrium that when altered expression of genes can lead to a variety of disease. For example, too little cell death can promote cell overgrowth a... Read full blog post. |
|
MAPK8/JNK1 - A multifunctional kinase and drug target for cancer therapeutics The c-Jun N-terminal kinase (JNK) family is a group of regulatory kinases with important functions in cell morphogenesis, inflammation, differentiation, and cell death (1). Aberrant activation of JNK family proteins in cancers has led to interest i... Read full blog post. |
|
p53 - Investigating an important tumor suppressor p53 is a tumor suppressor that has a central role in regulating cell cycle arrest, DNA repair, and apoptosis. p53 is widely studied for its role in cancer and is mutated or altered in more than half of all cancers (1). This widespread role in tumor... Read full blog post. |
|
Bcl-2 - an antiapoptotic protein with an important role in cancer cell survival B-cell lymphoma 2 (Bcl-2) protein is an oncogene that normally acts as an apoptotic inhibitor and localizes to the mitochondrial membrane where it prevents the release of cytochrome c. The Bcl-2 protein family consists of over 20 proteins each co... Read full blog post. |
|
Beclin 1 - A Key Regulator of Autophagosome Formation The Beclin 1 protein is a central regulator of autophagy in mammalian cells. Autophagy is an essential process used to maintain cellular homeostasis by degrading and recycling cellular components such as damaged or worn out organelles and macromole... Read full blog post. |
|
BNIP3 - a regulator of mitochondrial autophagy and cell death Bcl-2 nineteen-kilodalton interacting protein 3 (BNIP3) is a pro-apoptotic BH3-only protein. BNIP3 localizes to the mitochondrial membrane where it plays a key role in mitochondrial autophagy and cell death pathways. Similar to other Bcl-2 family m... Read full blog post. |
The concentration calculator allows you to quickly calculate the volume, mass or concentration of your vial. Simply enter your mass, volume, or concentration values for your reagent and the calculator will determine the rest.